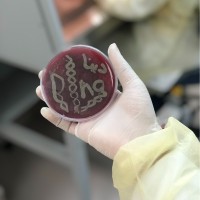
Dina M.

Company Details
- Employees
- 11
- Founded
- 2019
- Address
- Makkah, Taif 26311, Sa
- Industry
- Education Administration Programs
- NAICS
-
Administration of Education Programs
- Website
- https://t.me/BiologistGroup
- Keywords
- Chemistry, Biology, Biotechnology, Bioscience, Bioengineering, Marine science, Zoology, Molecular biology, Botany, Ecology, Genetics, Bio chemistry, Microbiology, Medical laboratory, And all related fields.
- HQ
- Makkah, Taif
- Competitors
- FSMLJ, King Abdulaziz City for Science and Technology (KACST), X-Genome Biotech Company, iGene, SFDA - هيئة الغذاء والدواء, NoorDx - Diagnostics & Discovery, SASO, Saudi Standards Metrology and Quality Organization, شركة العلوم | Science Company, NCECKSA, المركز الوطني للوقاية من الآفات النباتية والأمراض الحيوانية ومكافحتها.